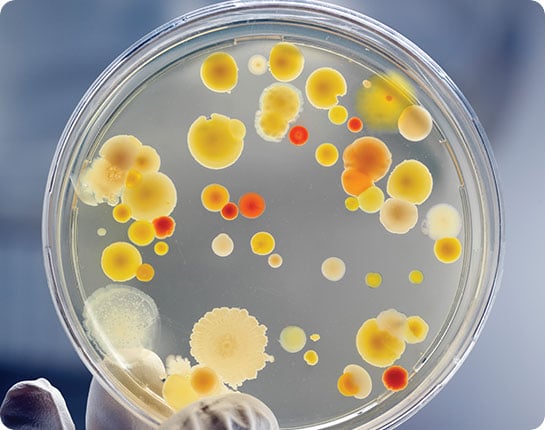

VIROLOGY Detail
You Can Find Us At:
3707 Westcenter Dr., # 100, Houston, TX 77042
VIROLOGY / BACTERIOLOGY
At Auspicious Labs.
At Auspicious Labs, we specialize in a variety of testing. From Covid Testing, Oral and Urine fluid drug testing, Forensic Toxicology, and more. We also provide accurate drug abuse testing and confirmation reports.
Physicians and other larger parties have worked up our lab time and time again. They can testify to the positive experience that they have had working with us. Our lab technicians and pharmaceutical scientists are highly experienced and are ready to work with you. We know that you will have a pleasant, professional, and timely experience with us.
What are Virology and Bacteriology Testing?
Virology and Bacteriology testing involves molecular biology. This specific testing is designed to detect viruses and bacteria that cause different sicknesses. A sample will be collected from a person, and from there, it will be taken to the lab. In the lab, technicians will search the sample for any evidence of a virus or bacteria.
For example, this process is how we test for Covid-19. A swap is placed in the nasal and is moved around to collect a sample. This sample is then taken to the laboratory, and the virus is searched for in the sample.
There are several different methods used to identify bacteria and viruses. At Auspicious Labs, we use real-time PCR testing. Used to detect most viruses, real-time PCR testing has been proven to work time and time again.
Proven viruses that this test has detected are Covid 19, Influenza (the Flu), Human Papillomavirus, and much more.
For more information about Virology and Bacteriology testing, call us today.
Different tests available to you
Our lab has many different panel tests. Each is designed to target and detect certain viruses and bacteria. Respiratory Panel tests and GI Panel tests are part of what we focus on and are able to provide.
Respiratory Panel Tests available to you
These tests have 2 targets. One being bacterial and the second being viral.
Examples of bacterial targets are Chlamydophila pneumoniae, Bordetella parapertussis, Bordetella pertussis, and Mycoplasma pneumoniae. In addition to these, there are more bacterial targets that are being researched and under development.
Examples of viral targets include Coronavirus (HKU1, NL63, 229e, OC43), SARS-CoV-2 (Covid 19), Adenovirus, Parainfluenza Virus(1-4), Respiratory Syncytial Virus, Influenza (A, A/H1, A/H2, A/H3, A/H1 2009, B), Human Rhinovirus/Enterovirus, and Human Metapneumovirus.
GI Panel Tests available to you
GI Panel tests have 4 targets. These being bacterial targets, viruses, parasites, and Diarrheagenic E.Coli/Shigella.
Examples of bacterial targets include Campylobacter, Clostridium difficile toxin A/B, Plesiomonas shigelloides, Salmonella, Vibrio, Vibrio Cholerae, and Yersinia enterocolitica.
Viruses examples are Adenovirus F 40/41, Astrovirus, Norovirus GI/GII, Rotavirus A, and Sapovirus.
Parasites target examples include Cryptosporidium, Cyclospora cayetanensis, Entamoeba histolytica, and Giardia lamblia.
Examples of Diarrheagenic E.Coli/Shigella are Enteroaggregative E. coli, Enteropathogenic E. coli, Enterotoxigenic E. coli, E. coli O157, Shiga-like toxin-producing E. coli, and Shigella/Enteroinvasive E. coli.
How fast can I have the results of my test?
Our goal here at Auspicious Labs is to have your test results in your hand as soon as possible. Depending on the test that you come in for, we can have your results in 24-48 hours. In the case of a Covid test, we can have your results ready in as little as just a couple of hours.
For Virology and Bacteriology testing, results will be made available in 24-48 hours. The time a result is received depends on what test is being done that day. We do our best to make sure that results are our during this time frame to have the information you need in a timely manner.
You can also get Covid testing at our lab. For covid testing, if you come into the lab before 11 AM, it is sure that you will have your test results ready at 4 or 5 PM. Come in anytime after 11 AM, and your test results will be available around noon the next day.
Some customers need rapid testing done for their covid test, and we provide this service. Results will be available for those who need this service in 1-2 hours. That way you can make your flight.
For additional questions on testing results, call our office, and a staff member will be ready to answer you. You can also ask about the costs of testing, and we will be glad to tell you the costs of the different tests we provide. Call us or send us an email today.
Virology and Bacteriology Testing
Our technicians are working around the clock to ensure that your test results arrive as quickly as possible. We here at Auspicious Labs have clients all over the Greater Houston area. More specifically, in the Eldridge Energy Corridor Briarforest, West Chase, China Town, and Westheimer, Alief, and Sharpstown areas.
You don’t want to have to go to a testing center that far from where you live. Our location is close to you, and we provide Covid 19 testing and any other testing you may be looking for.
Our lab is open Monday-Friday from 8 AM to 5 PM and on Saturday from 8 AM to 4 PM. The flexible office hours we have, allow you to come in at any time you are free. We want to accommodate your busy schedule, so there is no need to make an appointment ahead. Walk-ins are welcomed. And there are no long lines or prolonged waiting.
Visit us at Auspicious Lab for Virology and Bacteriology Testing.